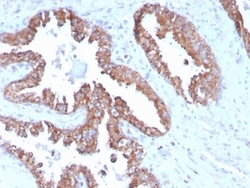

Antibody data
- Antibody Data
- Antigen structure
- References [0]
- Comments [0]
- Validations
- Immunohistochemistry [3]
- Protein array [1]
- Other assay [1]
Submit
Validation data
Reference
Comment
Report error
- Product number
- V7336 - Provider product page

- Provider
- NSJ Bioreagents
- Product name
- TMEPAI Antibody / PMEPA1
- Antibody type
- Monoclonal
- Description
- This highly specific TMEPAI antibody is suitable for use in Immunohistochemistry applications with human samples.
- Reactivity
- Human
- Host
- Mouse
- Conjugate
- Unconjugated
- Antibody clone number
- PMEPA1/2696
- Vial size
- 20 ug (with BSA and sodium azide), 100 ug (with BSA and sodium azide), 100 ug (without BSA or sodium azide), 7 ml IHC only format (if applicable)
- Concentration
- 0.2 mg/ml, 1 mg/ml
- Storage
- Store the TMEPAI antibody at 2-8oC (with azide) or aliquot and store at -20oC or colder (without azide).
No comments: Submit comment
Supportive validation
- Submitted by
- NSJ Bioreagents (provider)
- Main image
- Experimental details
- IHC staining of FFPE human prostate carcinoma with TMEPAI antibody (clone PMEPA1/2696). HIER: boil tissue sections in pH6, 10mM citrate buffer, for 10-20 min and allow to cool before testing.
- Submitted by
- NSJ Bioreagents (provider)
- Main image

- Experimental details
- IHC staining of FFPE human prostate carcinoma with TMEPAI antibody (clone PMEPA1/2696). HIER: boil tissue sections in pH6, 10mM citrate buffer, for 10-20 min and allow to cool before testing.
- Submitted by
- NSJ Bioreagents (provider)
- Main image

- Experimental details
- IHC staining of FFPE human colon carcinoma with TMEPAI antibody (clone PMEPA1/2696). HIER: boil tissue sections in pH6, 10mM citrate buffer, for 10-20 min and allow to cool before testing.
Supportive validation
- Submitted by
- NSJ Bioreagents (provider)
- Main image

- Experimental details
- Analysis of HuProt(TM) microarray containing more than 19,000 full-length human proteins using TMEPAI antibody (clone PMEPA1/2696). These results demonstrate the foremost specificity of the PMEPA1/2696 mAb.Z- and S- score: The Z-score represents the strength of a signal that an antibody (in combination with a fluorescently-tagged anti-IgG secondary Ab) produces when binding to a particular protein on the HuProt(TM) array. Z-scores are described in units of standard deviations (SD's) above the mean value of all signals generated on that array. If the targets on the HuProt(TM) are arranged in descending order of the Z-score, the S-score is the difference (also in units of SD's) between the Z-scores. The S-score therefore represents the relative target specificity of an Ab to its intended target.
Supportive validation
- Submitted by
- NSJ Bioreagents (provider)
- Main image

- Experimental details
- SDS-PAGE analysis of purified, BSA-free TMEPAI antibody (clone PMEPA1/2696) as confirmation of integrity and purity.